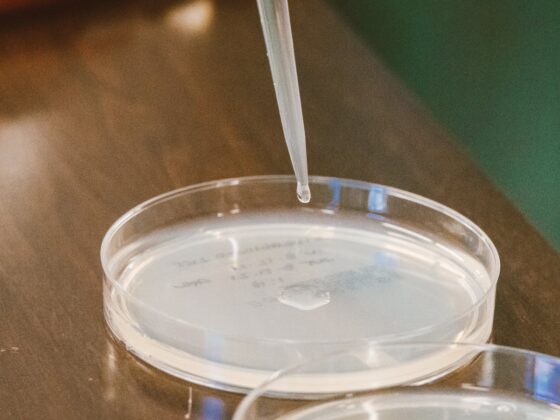

Head Coach Andy Enfield and the USC Trojans have landed the commitment of 2023 top 55 recruit and top ten center Arrinten Page. The Trojans have established themselves as a top recruiting program in the PAC-12 under Enfield. Page is not quite a “one and done” prospect, but should contribute to the team immediately with a chance at starting from day one. He could also help lure in his high school teammate and the number one point guard in the 2023 class, Isaiah Collier.
Breaking News: Arrinten Page tells ESPN, he has committed to USC. Page is no.55 overall in the class of 2023.
“It was a combination of their play style, coaching staff and what they have done with their big men in the past.” @arrintenp22 @tsfmack2023 & @WheelerHoops pic.twitter.com/WwaX9gUUHy
— Paul Biancardi (@PaulBiancardi) October 11, 2022
The Trojans are hoping to compete at the top levels of the PAC-12 until their eventual move to the Big Ten. Arrinten Page is a versatile big man who is listed as a center on recruiting websites but could play more power forward in college. He is currently listed at 6’9″ and 220 lbs. He is the second 2023 recruit to commit to the Trojans, joining four-star combo guard Silas Demary Jr.
2023 four-star Arrinten Page has committed to USC, he tells @On3Recruits. https://t.co/uTSUtKGjz0 pic.twitter.com/QBYC3sAKtx
— Joe Tipton (@TiptonEdits) October 11, 2022
The USC Trojans have established itself as a program that helps players get to the NBA and Arrinten Page plans to play in the NBA at some point. With the addition of talented four-star and five-star recruits the program should make the NCAA Tournament consistently and perhaps even compete in the later weekends of the event. Andy Enfield is building a talented program ahead of their move to the Big Ten.